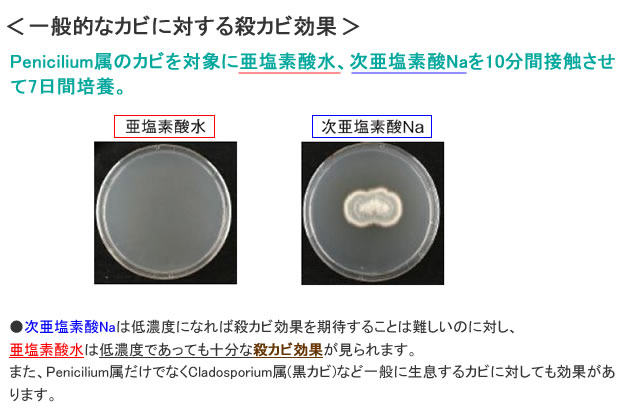
クロラス酸Nバリア 殺カビ 効果

クロラス酸Nバリア 1000ml 【第2類医薬品】 [細菌・ウイルス対策に 亜塩素酸水]
亜塩素酸水を成分とする 殺菌 消毒剤
厚生労働省の「新型コロナウイルスの消毒・除菌方法」や「保育所における感染症対策ガイドライン」などにも有効な成分として紹介されている「亜塩素酸水」を使った消毒・殺菌剤です。
※本品は【 第2類医薬品 】です。
クロラス酸Nバリア 1000ml 【第2類医薬品】 [細菌・ウイルス対策に 亜塩素酸水]
商品情報
| 商品コード | : | N75020100 |
|---|---|---|
| 出荷単位 | : | 1本(1000mL) |
| 販売価格 | : |
8,800
円(税込)
|
| 出荷関連 | : | 取り寄せ:1週間以内に出荷予定 |
クロラス酸Nバリアとは?
「保育所における感染症対策ガイドライン」や、厚生労働省の定める「新型コロナウイルス消毒・除菌方法一覧」などにも載っている有効成分「亜塩素酸水」を使った殺菌消毒液です。
各種モノ・部屋の消毒や殺菌する際にご使用いただけます。
★1本1000ml入りです。
★水で希釈して使用します(2倍または8倍希釈)
★塩素臭の付着がほとんどない。
★金属腐食が少ない。
- (1)汚れ・残渣など「有機物」が多く存在する環境下で効果を最大限に発揮
- (2)ノンエンベロープウイルスを含む、幅広い微生物に有効
- (3)pHを弱酸性に調整
- (4)有効成分として食品添加物:殺菌料 亜塩素散水を配合
| 効能・効果 | 用法・用量 |
|---|---|
| ・食品製造器具の消毒・殺菌 ・トイレの消毒・殺菌 ・シーツ・おむつの消毒・殺菌 ・ 室内・浴室の消毒・殺菌 ・調理器具・食器の消毒・殺菌 ・哺乳びん・乳首の消毒・殺菌 ・物品の消毒・殺菌 |
本品の8倍希釈液でする 清拭できない場合は数分間浸漬する |
| ・排泄物・おう吐物の消毒・殺菌 | 本品の2倍希釈液を用いる |
使用方法
■噴霧では使用しない
浸漬または清拭による使用をお願いいたします。
■換気をする
使用の際は、必ず換気をしてください。
酸性の製品やその他の製品と混合したり、併用しないこと
熱湯で希釈しないでください。
(1)バケツなどの容器を用意してください。
(2)本品を用意しボトル上部のキャップを左に回して開封してください。
(3)本品を計量カップで量り取りこれを水で薄めてください。(下表を目安にしてください)
(4)希釈液は必ずかき混ぜてから使用してください。
希釈倍率 |
用量 |
|---|---|
8倍 |
本品の量100mL+水の量700mL |
2倍 |
本品の量400mL+水の量400mL |
- 浸漬による殺菌・消毒
- 清拭による殺菌・消毒
(1)洗浄する
対象物をしっかり洗浄してください。(洗浄可能な対象物の場合)
(2)浸漬する
対象物を浸漬してください。
※5分以上~30分くらいで殺菌・消毒できます。
(3)乾燥する
浸漬液から取り出して、乾燥させてください。
※残液や残臭が気になる場合は、すすいでください。


(1)洗浄する
対象物をしっかり洗浄してください。(洗浄可能な対象物の場合)
(2)清拭する
希釈液を不織布などに染み込ませてから対象物を清拭してください。
※清拭後5分以上~30分くらいで殺菌・消毒できます。
(3)乾燥する
清拭で殺菌・消毒した後、水気を取り除いて、乾燥させてください。
※残液や残臭が気になる場合は、水を含ませて清拭してください。


(使用例) 嘔吐物・汚物の処理(厚生労働省 ノロウイルスQ&Aに基づく)
(1)汚物を除去する
汚物中のウイルスが飛び散らないように、嘔吐物・汚物をペーパータオル等で静かに拭き取ります。
(2)希釈液で拭き取る
2倍希釈液で浸すように床を拭き取ります。その後、水拭きしてください。
(3)換気する
嘔吐物・汚物は乾燥しないうちに床などに残らないよう速やかに処理し、処理した後はウイルスが屋外に出ていくよう
空気の流れに注意しながら十分な換気を行なってください。
(4)乾燥する
30分くらいで殺菌・消毒できますので、しっかりと乾燥させてください。


有効成分「亜塩素酸水」の特徴
- ウイルス・細菌・真菌・カビに効果
- 漂白しにくく、腐食性なし
- 消臭効果もあります
有効成分はクロラス酸(HClO2)となり、芽胞菌を含む細菌類やバクテリア、ウイルスに対して広範囲な除菌効果を有します。
・アルコールでは効き目が表れにくいカビ※(真菌類)に対しても抜群の効果を発揮します。
・ノロウイルスやインフルエンザ予防、害虫の発生源となるカビ対策などにも効果的です。

※アルコールでカビを除菌するには、70%以上のアルコールを2.5分間 乾燥させることなく接触させる必要があります。

漂白作用がほとんどなく、腐食性もありません。そのため、色落ちやステンレスの錆や金属腐食も気にせず使えます。

亜塩素酸水は消臭効果もあり、部屋のタバコ臭、ペット臭対策、トイレの消臭対策にも有効です。

使用上の注意

商品仕様
- ・成分分量:亜塩素散水20g/100ml(添加物として0.1mol/Lリン酸緩衝液使用)
- ・内容:1000mL
- ・メーカー:三慶(株)医薬部
- ・日本標準商品分類番号:877329
- ・薬事区分:第2類医薬品
- ・広告文責:薬剤師 武津一輔(TEL:072-691-5600、営業時間:平日9:00~17:30)
お買い物
クロラス酸Nバリア 1000ml 【第2類医薬品】 [細菌・ウイルス対策に 亜塩素酸水]
商品情報
| 商品コード | : | N75020100 |
|---|---|---|
| 出荷単位 | : | 1本(1000mL) |
| 販売価格 | : |
8,800
円(税込)
|
| 出荷関連 | : | 取り寄せ:1週間以内に出荷予定 |
ショッピングモールからもご購入いただけます
-
重要なお知らせ








送料・お支払い
会社概要
担当者紹介
FAX注文用紙
商品の返品










